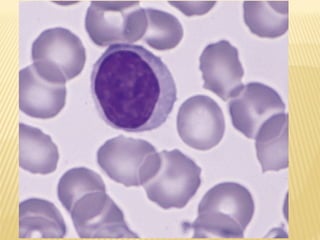
lesson 6

Документ описывает цель занятия, связанную с морфофункциональной характеристикой крови и лимфы, включая изучение их химического состава и компонентов. Учащиеся будут готовить мазок крови и изучать форменные элементы, а также проводить дифференциальный подсчет лейкоцитов. Контрольные вопросы касаются различных аспектов крови, включая классификацию форменных элементов и их функции.